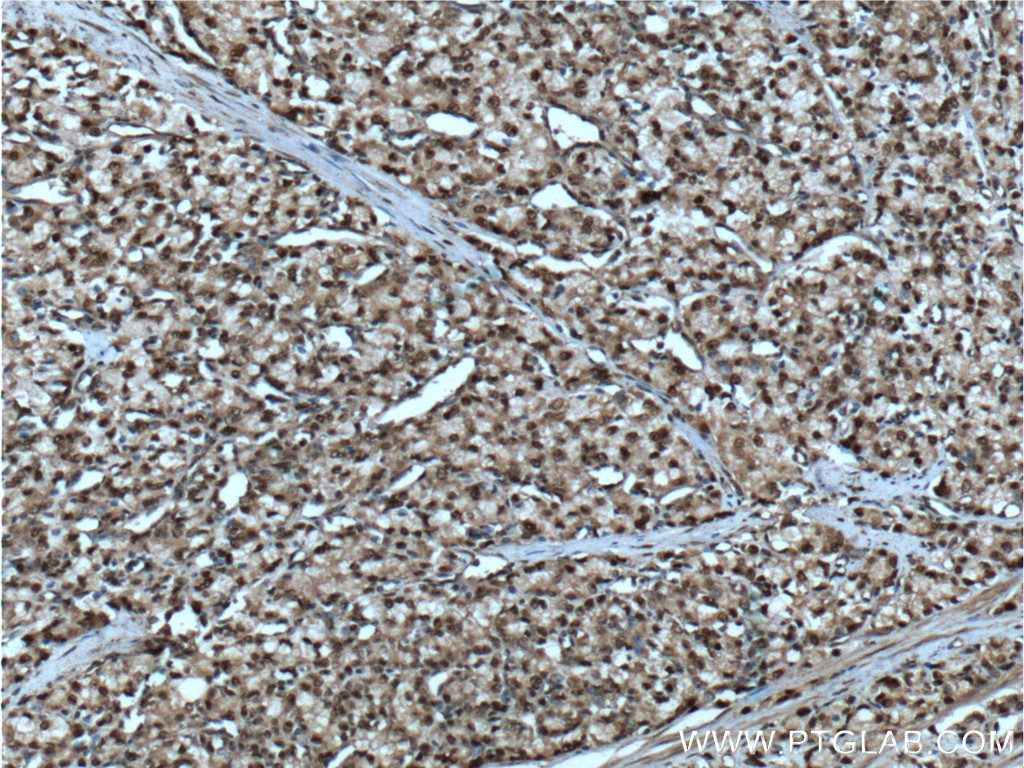

验证数据展示
经过测试的应用
| Positive WB detected in | HepG2 cells, K-562 cells |
| Positive IP detected in | K-562 cells |
| Positive IHC detected in | human lymphoma tissue, human prostate cancer tissue Note: suggested antigen retrieval with TE buffer pH 9.0; (*) Alternatively, antigen retrieval may be performed with citrate buffer pH 6.0 |
推荐稀释比
| 应用 | 推荐稀释比 |
|---|---|
| Western Blot (WB) | WB : 1:500-1:2000 |
| Immunoprecipitation (IP) | IP : 0.5-4.0 ug for 1.0-3.0 mg of total protein lysate |
| Immunohistochemistry (IHC) | IHC : 1:20-1:200 |
| It is recommended that this reagent should be titrated in each testing system to obtain optimal results. | |
| Sample-dependent, Check data in validation data gallery. | |
产品信息
20654-1-AP targets SMARCB1 in WB, IHC, IF, IP, ELISA applications and shows reactivity with human samples.
| 经测试应用 | WB, IP, IHC, ELISA Application Description |
| 文献引用应用 | WB, IF |
| 经测试反应性 | human |
| 文献引用反应性 | human |
| 免疫原 |
Peptide 种属同源性预测 |
| 宿主/亚型 | Rabbit / IgG |
| 抗体类别 | Polyclonal |
| 产品类型 | Antibody |
| 全称 | SWI/SNF related, matrix associated, actin dependent regulator of chromatin, subfamily b, member 1 |
| 别名 | BAF47, BRG1 associated factor 47, hSNF5, hSNFS, INI1, INI-1, Integrase interactor 1 protein, RDT, Sfh1p, SMARCB1, SNF5, SNF5 homolog, SNF5L1, Snr1 |
| 计算分子量 | 44 kDa |
| 观测分子量 | 40-45 kDa |
| GenBank蛋白编号 | NM_003073 |
| 基因名称 | SMARCB1 |
| Gene ID (NCBI) | 6598 |
| RRID | AB_10695761 |
| 偶联类型 | Unconjugated |
| 形式 | Liquid |
| 纯化方式 | Antigen affinity purification |
| UNIPROT ID | Q12824 |
| 储存缓冲液 | PBS with 0.02% sodium azide and 50% glycerol, pH 7.3. |
| 储存条件 | Store at -20°C. Stable for one year after shipment. Aliquoting is unnecessary for -20oC storage. |
背景介绍
SMARCB1, also named as BAF47, INI1 and SNF5L1, belongs to the SNF5 family. It is a core component of the BAF (hSWI/SNF) complex. The BAF complex is able to create a stable, altered form of chromatin that constrains fewer negative supercoils than normal. SMARCB1 stimulates in vitro the remodeling activity of SMARCA4/BRG1/BAF190A. It is involved in activation of CSF1 promoter. SMARCB1 belongs to the neural progenitors-specific chromatin remodeling complex (npBAF complex) and the neuron-specific chromatin remodeling complex (nBAF complex). During neural development a switch from a stem/progenitor to a post-mitotic chromatin remodeling mechanism occurs as neurons exit the cell cycle and become committed to their adult state. SMARCB1 plays a key role in cell-cycle control and causes cell cycle arrest in G0/G1. It is also involved in vitamin D-coupled transcription regulation via its association with the WINAC complex, a chromatin-remodeling complex recruited by vitamin D receptor (VDR), which is required for the ligand-bound VDR-mediated transrepression of the CYP27B1 gene. Defects in SMARCB1 are a cause of rhabdoid tumor (RDT) which also known as malignant rhabdoid tumor (MRT). Defects in SMARCB1 are a cause of schwannomatosis. The antibody is specific to SMARCB1.
实验方案
| Product Specific Protocols | |
|---|---|
| IHC protocol for SMARCB1 antibody 20654-1-AP | Download protocol |
| IP protocol for SMARCB1 antibody 20654-1-AP | Download protocol |
| WB protocol for SMARCB1 antibody 20654-1-AP | Download protocol |
| Standard Protocols | |
|---|---|
| Click here to view our Standard Protocols |
发表文章
| Species | Application | Title |
|---|---|---|
Nat Cell Biol Single-cell reconstruction of the adult human heart during heart failure and recovery reveals the cellular landscape underlying cardiac function. | ||
Front Cell Dev Biol Upregulation of Neogenin-1 by a CREB1-BAF47 Complex in Vascular Endothelial Cells is Implicated in Atherogenesis.
| ||
Transl Oncol SNF5, a core subunit of SWI/SNF complex, regulates melanoma cancer cell growth, metastasis, and immune escape in response to matrix stiffness. | ||
Bioengineered SNF5 promotes cell proliferation and immune evasion in non-small cell lung cancer.
| ||
Acta Biochim Biophys Sin (Shanghai) A novel mutation in SMARCB1 associated with adult Coffin-Siris syndrome and meningioma | ||
Sci Rep SMARCB1 orchestrates cellular plasticity and oncogenic pathways in typical and chondroid chordomas |